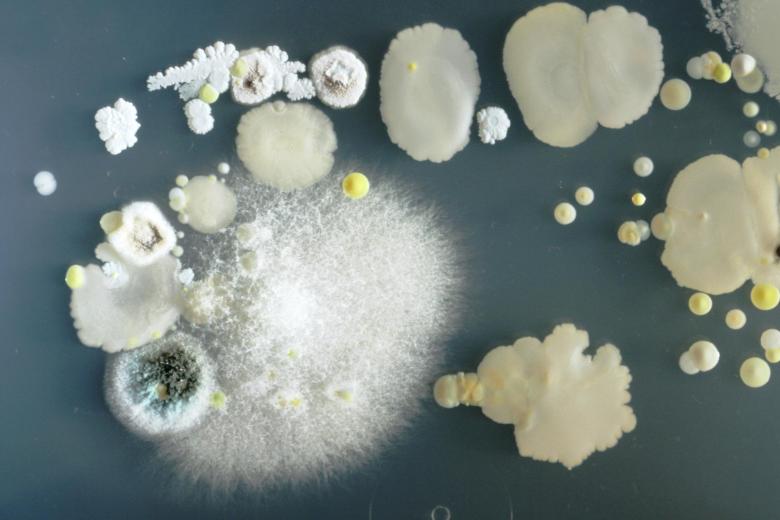

Ob beim Sport, im Büro, beim Kochen oder sogar auf der Toilette, Smartphones sind zu einem ständigen Begleiter geworden und aus dem Alltag nicht mehr wegzudenken. Studenten und Wissenschaftler haben Handydisplays nun näher auf Bakterien untersucht, die sich dort tagtäglich ungesehen ansammeln.
Für ihren Versuch drückten die Biologiestudenten an der Universität in Guildford ihre eigenen Smartphones in eine Petrischale und ließen diese Probe drei Tage lang bei eine konstanten Temperatur von 37 Grad wachsen. Die danach entstandenen Fotos sehen zwar zunächst erschreckend aus, bei den meisten Bakterien soll es sich allerdings nur um harmlose Keime handeln, die typische Bewohner der menschlichen Haut sind.
Allerdings zeigten die Proben Bakterien, die man eher weniger auf dem Display seines Smartphones erwarten würde. So sollen auf jedem sechsten Gerät Spuren von Fäkalien gefunden worden sein und auch ansteckende Keime wie der Staphylococcus aureus waren nicht selten.
Anlässlich einer Forschung zu gefährlichen Keimzellen auf Telefonen von Klinikpersonal, beschäftigten sich auch die Wissenschaftler der Hochschule Furtwangen mit den Bildschirmen von Smartphones. Sie kamen zu einem ähnlichen Ergebnis wie die Kollegen aus Guildford und fanden nicht nur Erreger harmloser Hautirritationen, sondern auch Überträger von tödlichen Krankheiten. Auf jedem achten untersuchten Gerät fanden sich sogar Antibiotikaresistenz Keime.

Regelmäßiges reinigen hilft
Auch nach der besten Möglichkeit um die Mikroorganismen wieder loszuwerden gingen die Forscher auf die Spur. Markus Egert, Fakultätsprofessor in Furtwangen, verglich dazu die Keimbelastung von Smartphone die nicht gereinigt wurden, mit solchen, die entweder mit einem feuchten Brillenputztuch oder einem trockenen Mikrofasertuch gesäubert wurden. Keines der beiden Reinigungstücher konnte die Bakterien vollständig beseitigen. So konnte das Brillenputztuch nur auf jedem dritten und das Mirkofasertuch sogar nur auf jedem vierten Telefon die Keime vollständig entfernen.
Zu einem besseren Reinigungsergebnis könnten spezielle Displayreiniger wie das ProIdee Spray führen. Auf aggressive Mittelchen oder desinfizierende Lösungen deren Materialverträglichkeit unbekannt ist, sollte jedoch besser verzichtet werden.

